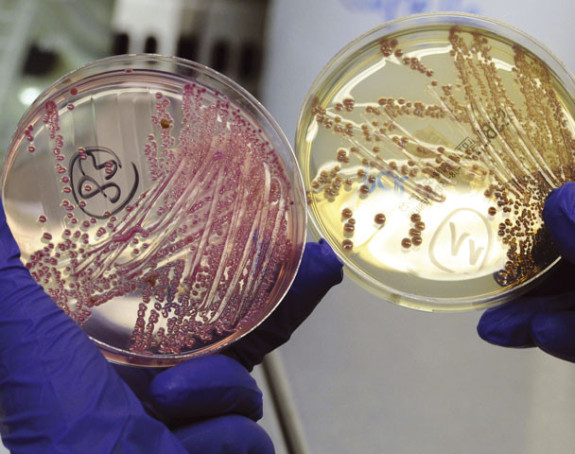
25.000 ljudi umre od rezistentnih bakterija

Magazin / Zdravlje


petak, 13.11.2015 | 10:30
Dijabetes ubija više ljudi nego HIV, tuberkuloza i malarija






ponedeljak, 09.11.2015 | 15:00
Porodila se sat vremena nakon što je saznala da je trudna






četvrtak, 05.11.2015 | 13:00
U provjetrenim kancelarijama bolje se misli, pamti i shvata

Babalj poručio: Zlonamjernici ništa vam nije sveto, samo ste dokazali koliko ste sitni i bijedni
18.03.2026 | 07:56